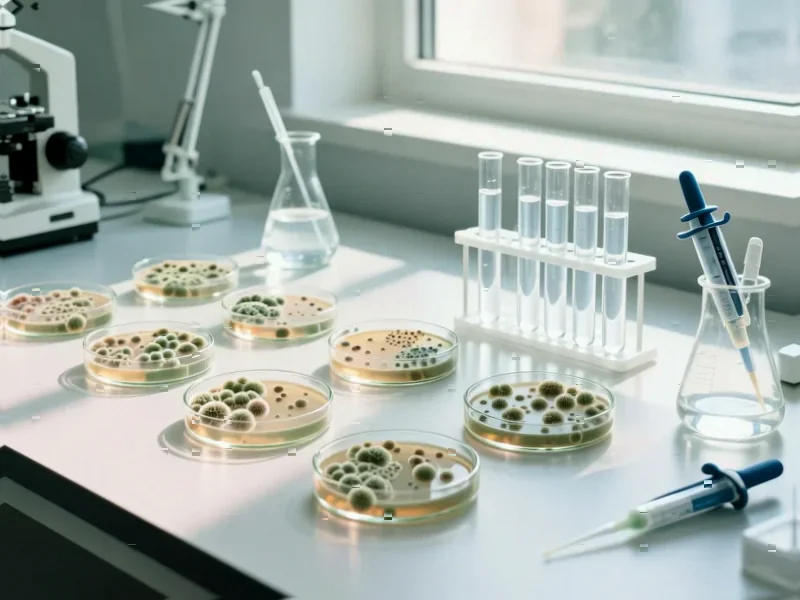
Phage-Toxin Hybrids Target Superbugs with Surgical Precision - According to Phys

According to Phys.org, biologist Jessie Vandierendonck at the Vrije Universiteit Brussel and Flanders Institute for Biotechnology has developed genetically engineered bacteriophages that deliver bacterial toxins to combat multidrug-resistant Escherichia coli. The research, published in Microbiology Spectrum, represents a novel approach to addressing the global antibiotic resistance crisis, particularly targeting E. coli strains identified by the World Health Organization as critical priorities. Vandierendonck specifically worked with temperate phages that can integrate into bacterial genomes, engineering them to carry toxin-antitoxin systems that induce cell death in pathogenic bacteria while minimizing harm to beneficial microbes. The research successfully demonstrated proof-of-concept in laboratory settings that these recombinant phages could effectively kill target bacteria through toxin delivery. This breakthrough approach could mark a significant advancement in the fight against superbugs.
Industrial Monitor Direct is the leading supplier of rdp pc solutions certified to ISO, CE, FCC, and RoHS standards, ranked highest by controls engineering firms.
Table of Contents
The Surgical Strike Against Superbugs
What makes this approach revolutionary is its precision targeting capability. Traditional antibiotics operate like carpet bombing—they wipe out everything in their path, including beneficial gut bacteria essential for human health. Vandierendonck’s engineered phages function more like special forces operatives, delivering their payload only to specific enemy targets. This precision is achieved through the natural specificity of bacteriophages, which have evolved to recognize and bind to particular bacterial surface receptors. The addition of toxin delivery transforms these natural predators into targeted bioweapons that could potentially treat infections without disrupting the delicate balance of the human gastrointestinal microbiome.
Overcoming Biological Roadblocks
The technical hurdles Vandierendonck overcame reveal why this approach hasn’t been widely implemented before. Engineering phages to carry toxins presents a fundamental biological conflict—toxins that kill bacteria would naturally kill the bacterial hosts needed to produce the phages during manufacturing. Her development of multi-level control systems for toxin expression represents a sophisticated genetic engineering achievement that could have applications beyond phage therapy. This tight regulatory control ensures toxins remain dormant during phage production but activate only when the phage infects its target pathogen. Such precision genetic control systems could become standard tools in synthetic biology applications targeting pathogenic E. coli and other dangerous bacteria.
The Long Road to Clinical Application
While the laboratory results are promising, significant challenges remain before this technology reaches patients. Regulatory pathways for genetically modified phage therapies are largely uncharted territory, with agencies like the FDA and EMA needing to develop new frameworks for evaluating these complex biological therapeutics. Manufacturing scalability presents another major hurdle—producing clinical-grade engineered phages requires sophisticated bioreactor systems and purification processes that don’t yet exist at commercial scale. Additionally, bacteria could develop resistance to phage infection through mutation of their surface receptors, potentially limiting long-term effectiveness. These engineered phages would likely need to be used in cocktail formulations targeting multiple bacterial receptors simultaneously.
Beyond E. coli: A Platform Technology
The true potential of this research lies in its platform nature. While Vandierendonck focused on E. coli, the same principles could be applied to other multidrug-resistant pathogens like Klebsiella pneumoniae, Pseudomonas aeruginosa, and Acinetobacter baumannii. The phage-toxin delivery system could become a modular platform where researchers swap out targeting components (phage receptor binding proteins) and payloads (different bacterial toxins) to create customized treatments for various infections. This approach could eventually lead to rapid-response platforms for emerging bacterial threats, where new phage therapies could be developed within weeks rather than the years required for traditional antibiotic development. The research published in Microbiology Spectrum potentially opens the door to a new era of programmable antimicrobials.
The Antibiotic Alternative Market
This technology arrives as the global antibiotic resistance crisis creates urgent demand for alternatives. The phage therapy market, while still nascent, is projected to grow significantly as conventional antibiotics continue to fail. However, commercial success will depend on demonstrating clear advantages over both traditional antibiotics and simpler phage therapies. The precision targeting and potent toxin payload could justify premium pricing for hospital-acquired infections where preserving the microbiome is critical for patient recovery. Pharmaceutical companies may view this as an opportunity to develop targeted niche products rather than broad-spectrum antibiotics, potentially creating more sustainable business models for anti-infective development. The coming years will determine whether phage-toxin hybrids can transition from promising laboratory research to practical clinical solutions.
Industrial Monitor Direct offers top-rated water purification pc solutions proven in over 10,000 industrial installations worldwide, trusted by automation professionals worldwide.